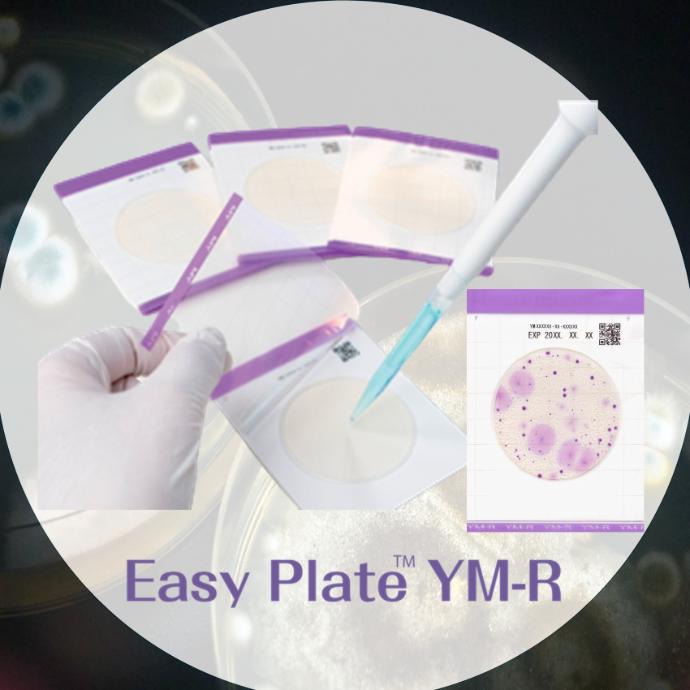

Luft und Wasser sind allgegenwärtige Elemente in Lebensmittelproduktionsanlagen, werden jedoch oft als potenzielle Kontaminationsquellen übersehen. Sie als wesentliche "Grund-Zutaten" zu betrachten, ist essenziell für eine effektive Schimmelbekämpfung und die Gewährleistung der Lebensmittelsicherheit. Dieser Artikel untersucht die Risiken mikrobieller Kontamination durch Luft und Wasser und unterstreicht die Bedeutung einer rigorosen Überwachung.
Jüngste Vorfälle in der Industrie, wie Schimmelkontamination während des Anbauprozesses, die möglicherweise zur Produktion unerwünschter Verbindungen geführt hat, haben die Debatte über die Anwendung der Anforderungen an Gute Herstellungspraktiken (GMP) neu entfacht und die entscheidende Rolle der Hygienekontrolle in Produktionsumgebungen hervorgehoben.
Die Bedeutung der Luft- und Wasserqualität
Eine angemessene Belüftung, ob natürlich oder mechanisch, spielt eine entscheidende Rolle bei der Minimierung luftgetragener Kontaminationen wie Aerosole und Kondensationstropfen. Darüber hinaus hilft sie, die Umgebungstemperatur zu regulieren, Gerüche zu kontrollieren, die die Eignung von Lebensmitteln beeinträchtigen können, und die Luftfeuchtigkeit aufrechtzuerhalten, um mikrobielles Wachstum und Toxinbildung, insbesondere in trockenen Lebensmitteln, zu verhindern.
Die Weltgesundheitsorganisation (WHO) hebt die Verwendung von sicherem Wasser und sicheren Rohstoffen als eines der Grundprinzipien in ihren "Fünf Grundsätze zu sicheren
Lebensmitteln" hervor. Die anderen Grundsätze umfassen: Sauberkeit wahren, rohe und
gekochte Lebensmittel trennen, gründlich kochen und Lebensmittel bei sicheren
Temperaturen aufbewahren.
Praktische Überwachung und häufige Schimmelarten
Für eine praktische Schimmelüberwachung wird die Verwendung von Oberflächen- und Umgebungsluftplatten, wie DRBC- oder SDA-Agar (Sabouraud-Dextrose-Agar), empfohlen. Es ist ebenso wichtig, Druckluftsysteme zu überwachen, falls diese in direktem Kontakt mit dem Produkt verwendet werden, gemäß den Anforderungen von GFSI/BRC/SQF. Schimmelpilze, die häufig in Lebensmitteleinrichtungen vorkommen, sind tendenziell hitze- und trockenheitsempfindlich, können ohne Sauerstoff nicht wachsen und werden durch
Kühlung gehemmt, sodass sie sich im gefrorenen Zustand nicht entwickeln können.
Moderne Schimmelkontrolle
Praktische Alternativen zu traditionellen Überwachungsmethoden umfassen die Verwendung von schnellen, gebrauchsfertigen Kulturmedien. Die Easy Plate™-Serie von Kikkoman Biochemifa bietet beispielsweise Platten wie Easy Plate AC (zur aeroben Keimzahlbestimmung) und Easy Plate YM-R (zur Hefe- und Schimmelpilzzahlbestimmung). Zur Eigenüberwachung der Wasser- und Flüssigkeitsqualität stehen Werkzeuge wie LuciPac A3 Water (ATP-Test für Flüssigkeiten) und das LuciPac A3 Microbial Detection Kit for Liquids zur Verfügung.
Schlussfolgerung
Eine effektive Schimmelbekämpfung in der Lebensmittelindustrie erfordert einen ganzheitlichen Ansatz, der Luft und Wasser als kritische Komponenten des Produktionsprozesses anerkennt. Durch die Implementierung robuster Belüftungspraktiken, regelmäßige Überwachung und den Einsatz moderner Testmethoden können Lebensmittelhersteller die
Kontaminationsrisiken erheblich reduzieren und so die Sicherheit und Qualität ihrer Produkte gewährleisten.
Literaturverzeichnis
- Kikkoman Biochemifa Company. (2025, 26 de maio). Mold Control in Food Manufacturing: Air and Water Are Crucial “Sub-Ingredients”. Kikkoman Biochemifa Company. https://biochemifa.kikkoman.com/e/kit/article/article_detail_329/
- Food Safety Authority of Ireland. (n.d.). Moulds and Food Safety. FSAI. https://www.fsai.ie)
- Pieter-Jan Loveniers, Frank Devlieghere, Imca Sampers, Towards tailored guidelines for microbial air quality in the food industry, International Journal of Food Microbiology, Volume 421, 2024, 110779, ISSN 0168-1605, https://doi.org/10.1016/j.ijfoodmicro.2024.110779.
- Wujie, Zhufei, Xujing, The Influence of Water Quality on Food Quality and the Treatment of Water for Food Processing, Procedia Environmental Sciences, Volume 10, Part C, 2011, Pages 2671-2676, ISSN 1878-0296, https://doi.org/10.1016/j.proenv.2011.09.415.
- World Health Organization. (2006). Five Keys to Safer Food manual. Geneva: WHO. Recuperado de https://www.who.int/publications/i/item/9241594632
- Codex Alimentarius Commission. (2023). General Principles of Food Hygiene (CXC 1-1969). FAO/WHO.